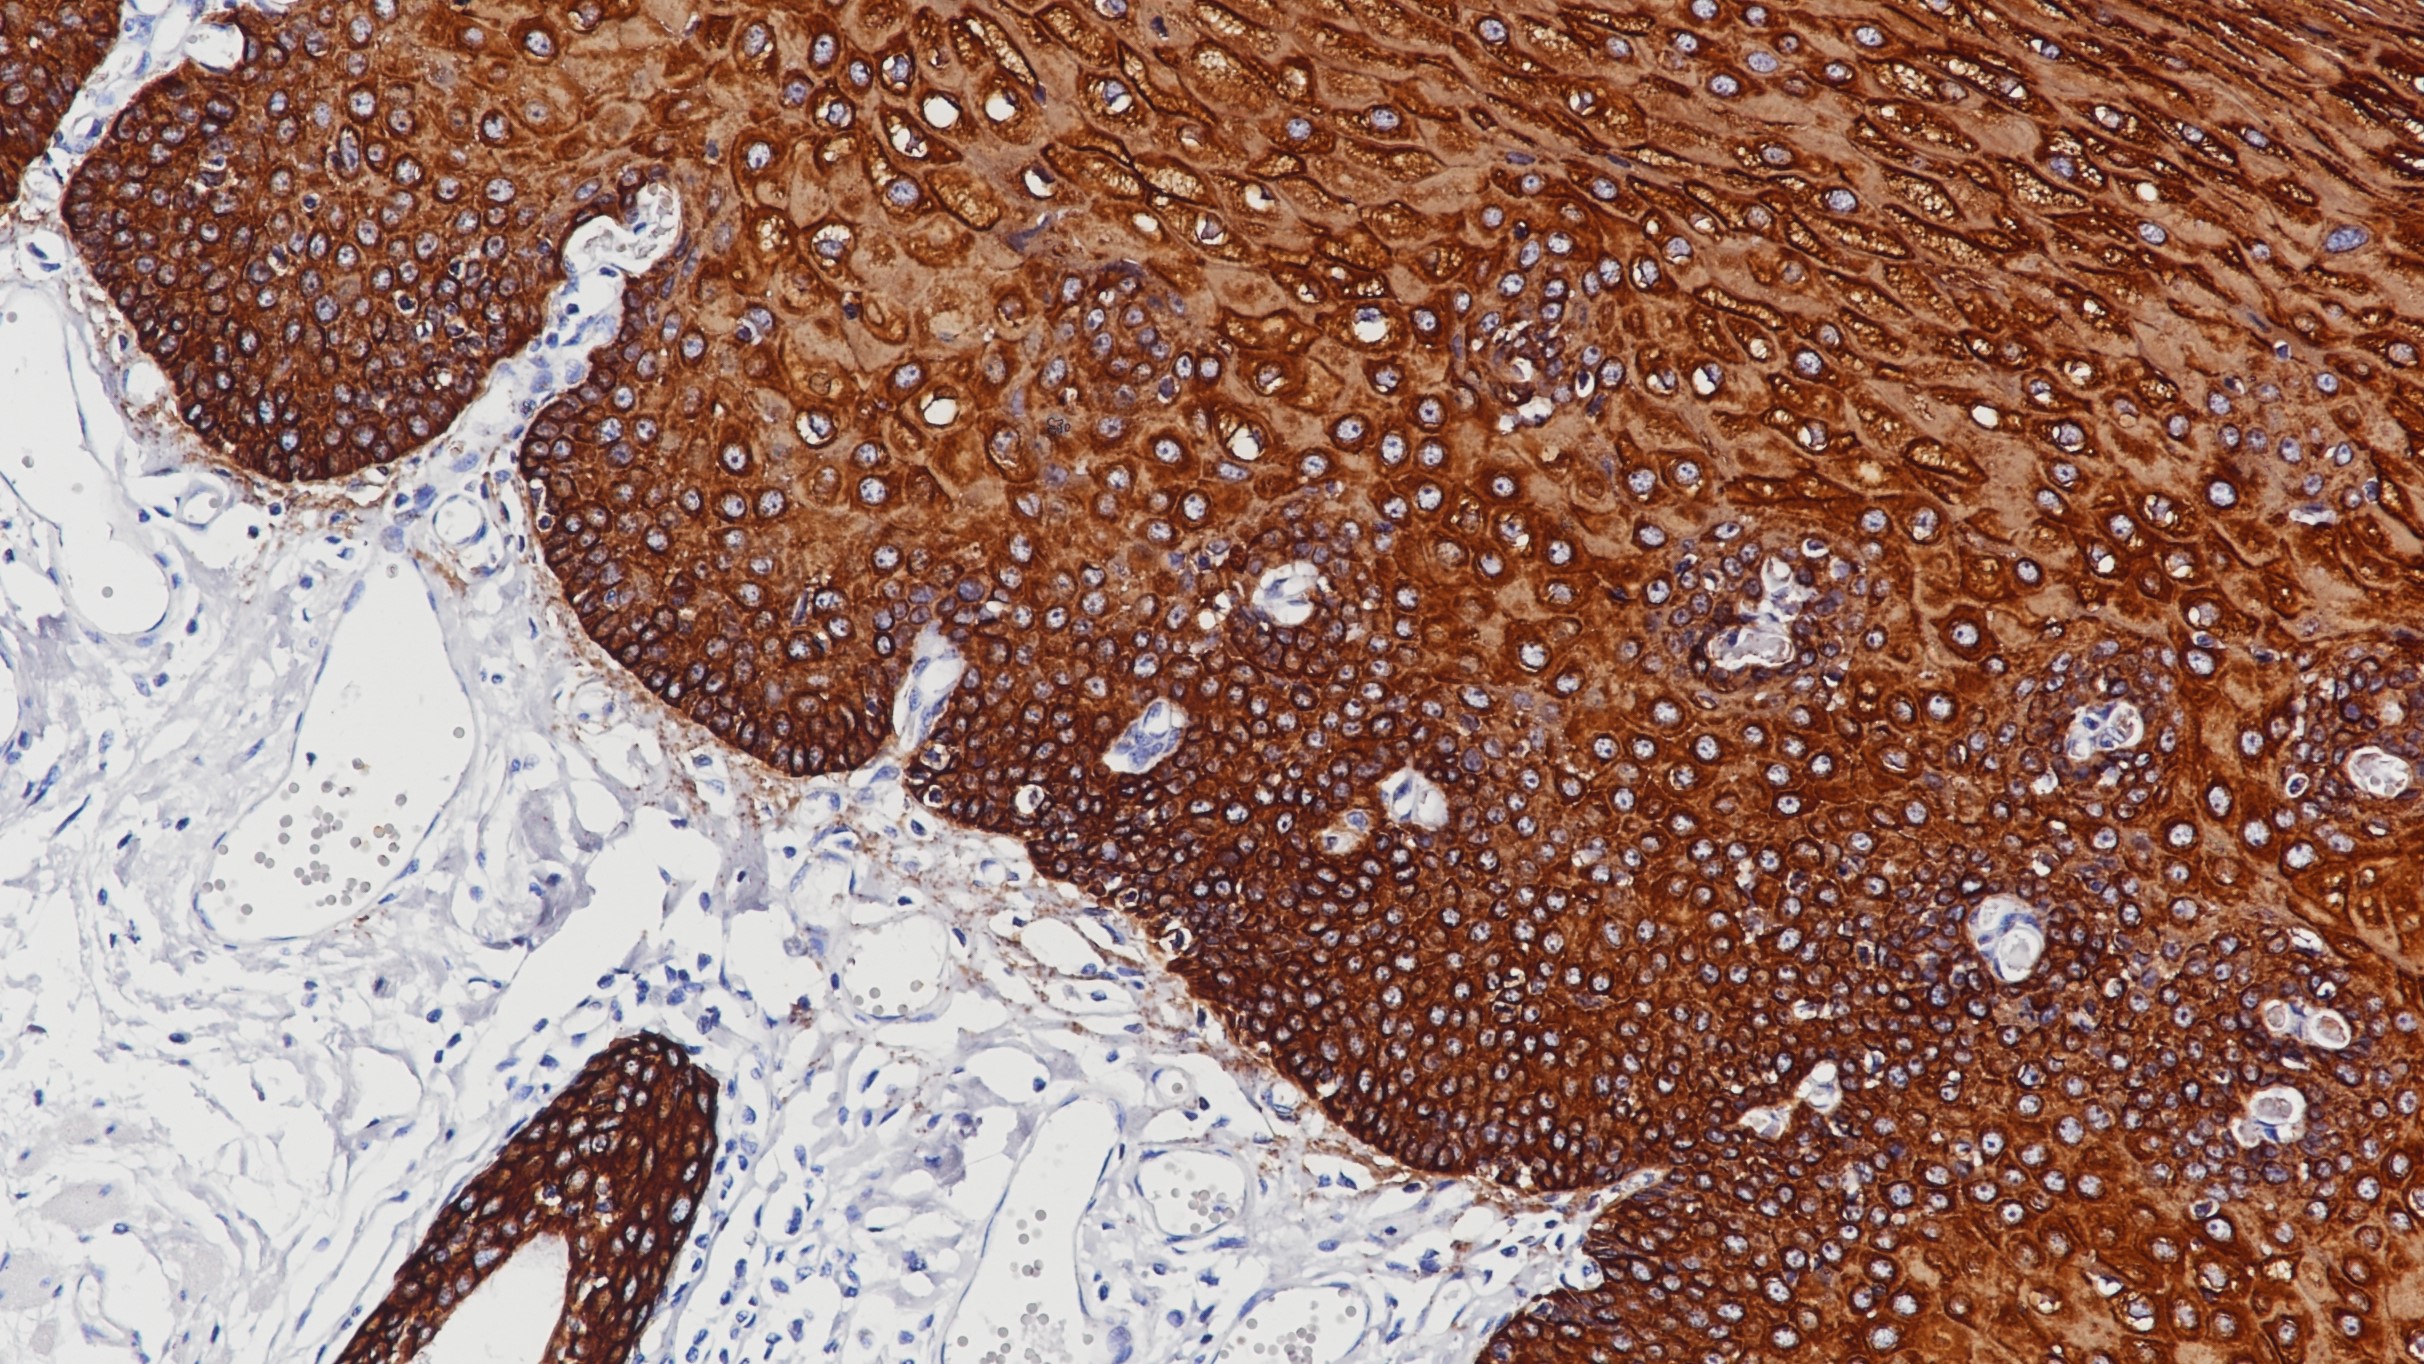
食道CK Pan (BP6051&6058)染色

1.Kriho UK, et al. Keratin expression in astrocytomas: An immunofluorescent and biochemical reassessment. Virehows Arch. 1997; 431:139-47.
2.A Gown, A Vogel. Monoclonal antibodies to intermediate Filament proteins of human cells: unique and cross-reacting antibodies. The Journal of Cell Biology-Volume 95, 1982;414-424.